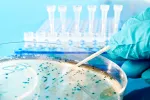
Diagnóstico de la leishmaniasis

Síntomas y tipos de leishmaniasis

Por: Dr. Nelson Caballero
Colaborador de la Asociación Fontilles y coordinador médico de la Asociación para el Desarrollo de los pueblos (ADP)
Actualizado: 22 de septiembre de 2022
La sintomatología de la leishmaniasis es variable, puede ir desde cuadros benignos hasta más severos, dependiendo de la cepa de la Leishmania infectante, el medioambiente, y la respuesta inmune del huésped.
Actualmente se describen cinco formas clínicas de presentación:
Leishmaniasis cutánea clásica
Es la forma más común y se presenta sobre todo en zonas montañosas con abundante vegetación y humedad.
Su localización es más frecuente en las partes expuestas del cuerpo, especialmente la cara y las extremidades.
En la zona de la picadura del flebótomo infectado, inicialmente aparece una pápula que tiende a crecer y que, en el término de dos a cuatro semanas, dará lugar a un nódulo pequeño e indoloro de cuyo centro posteriormente se desprende una costra, apareciendo entonces una úlcera espontánea, redondeada, indolora, de base indurada y fondo limpio color rosado, cuyos bordes bien definidos, elevados y cortados en forma de sacabocado, recuerdan la imagen del cráter de un volcán.
La úlcera puede ser única o múltiple, y pueden aparecer lesiones satélites alrededor de la lesión primaria. Cuando esta se infecta secundariamente por agentes piógenos (que hacen supurar) se torna purulenta y muy dolorosa.
Con frecuencia se ven afectados los ganglios linfáticos, causando cuadros de linfangitis y linfadenitis regionales.
En los primeros meses de evolución la úlcera crece hasta cierto tamaño en dependencia de la respuesta inmune del huésped y de la cepa de Leishmania infectante. A medida que comienza a prevalecer la respuesta inmune del huésped, la enfermedad tiende a evolucionar hacia la curación espontánea o, de lo contrario, se torna crónica.
Al curar la úlcera, esta siempre deja una cicatriz con daños físicos, e incluso muchas veces psicológicos, en la persona afectada.
Leishmaniasis mucocutánea o espundia
Se presenta meses o años después de que una persona haya padecido la forma cutánea clásica. Los parásitos se diseminan por vía linfática y sanguínea a partir de la lesión cutánea inicial cicatrizada, invadiendo las mucosas de la región nasal y oro faríngea.
Aparece en un porcentaje muy pequeño de casos, y el ataque ocurre cuando existe un desequilibrio inmunológico o fisiológico, o como producto de un trauma directo en nariz o boca.
Las lesiones mucosas se inician habitualmente a nivel del tabique nasal; no obstante, pueden comenzar en otras partes de las vías aéreas superiores y consisten en un infiltrado inflamatorio crónico, que se extiende rápidamente pudiendo perforar y destruir el tabique nasal, los labios, el paladar, la nasofaringe y la laringe, provocando con ello gran dificultad para tragar y hablar, e incluso hasta la muerte, debido a las complicaciones bacterianas o micóticas secundarias.

Esta forma nunca cura espontáneamente. Las lesiones pueden persistir durante muchos años de no ser tratadas y, una vez que la infección está curada, el afectado requiere por lo general de cirugía reconstructiva.
Leishmaniasis cutánea difusa
Es una forma rara de la enfermedad caracterizada por la ausencia en el huésped de una respuesta inmune mediada por células frente al parásito, lo que lleva a una reproducción incontrolada del mismo, originando la aparición de gran cantidad de pápulas, placas o nódulos, diseminados por toda la superficie corporal.
Su evolución es lenta y no cura espontáneamente; además, los enfermos tienden a la recaída después del tratamiento.
En el Viejo Mundo esta forma es producida por la L. aethiopica. En el Nuevo Mundo los agentes causales son: la L. amazonensis, L. mexicana y L. braziliensis.
Leishmaniasis visceral
También conocida como Kala-Azar. El principal reservorio de esta forma es el perro doméstico, y sin diagnóstico y tratamiento oportuno su tasa de mortalidad es muy elevada.
Después de un periodo de incubación de dos a cuatro meses tras la picadura del flebótomo infectado con cepas del complejo L. donovani o L. infantum (Viejo Mundo) y L. chagasi (Nuevo Mundo) comienzan las manifestaciones clínicas de la enfermedad, caracterizadas por un cuadro febril elevado, inicialmente remitente o intermitente, que dura varias semanas para, posteriormente, tornarse persistente y acompañarse de un deterioro progresivo del estado general del enfermo debido a la afectación del bazo, hígado, ganglios linfáticos y médula ósea.
Como complicación asociada, por lo general aparecen cuadros diarreicos agudos, que alternan con episodios disentéricos, sangrado nasal, infecciones de las vías urinarias y neumonías.
En pacientes infectados con el virus de la inmunodeficiencia humana (VIH), suele aparecer como una infección oportunista.
Los niños menores de cinco años, sobre todo si están malnutridos, son los más afectados. En ellos el adelgazamiento del tórax y los miembros contrasta con el crecimiento exagerado del abdomen debido al aumento exagerado de bazo e hígado.
Presentan una progresiva pérdida de peso hasta llegar a la caquexia (estado de extrema desnutrición). La palidez cutánea mucosa es profusa a causa de la anemia. Además, la presencia de manchas despigmentadas o hiperpigmentadas y nódulos voluminosos en la piel es frecuente.
Leishmaniasis atípica cutánea
Es una variante de la leishmaniasis cutánea clásica muy poco conocida, descrita en países de la región centroamericana, en concreto, Nicaragua, Honduras y Costa Rica. Afecta mayormente a los niños y adolescentes.
Se manifiesta por escasas lesiones no ulceradas en forma de pápulas, nódulos y placas asintomáticas, usualmente rodeadas de un halo despigmentado, que afectan predominantemente la cara y las extremidades.
A pesar de tener una evolución larga y benigna, existe el riesgo de que el parásito provoque una leishmaniasis visceral, sobre todo en los niños menores de dos años malnutridos, o con otros estados de inmunodepresión, por el hecho de tener ambas el mismo agente causal, en este caso la cepa chagasi. Igualmente comparten como principal reservorio al perro doméstico.
Creado: 26 de septiembre de 2011